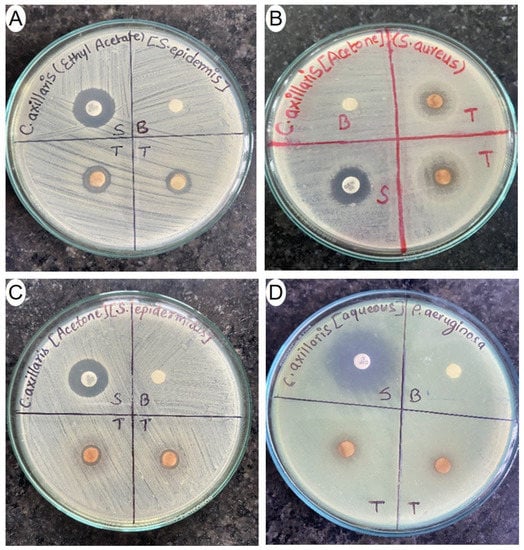

Abstract
Choerospondias axillaris Roxb. (Anacardiaceae) is a deciduous tree, native to Nepal and the Himalayan region, that can reach a maximum height of 20 m. The study aimed to assess the total phenol, flavonoid, and carbohydrate content, and preliminary antioxidant potency, xanthine oxidase inhibition, and antibacterial properties of C. axillaris fruits extracts. Ethyl acetate, acetone, methanol, and water were used as extraction solvents. The quantitative analysis showed that the extracts had total polyphenols (68.28 μg to 154.91 μg gallic acid equivalent/mg extract), flavonoids (41.72 to 283.84 μg quercetin equivalent/mg extract), and carbohydrates contents (67.26 µg to 269.96 µg glucose equivalent/mg extract). The acetone extract exhibited the highest antioxidant activity (IC50: 15.72 µg/mL) and potent inhibition of xanthine oxidase (IC50: 20.80 µg/mL) among the extracts. The acetone extract exhibited the strongest antibacterial efficacy against Staphylococcus aureus and Bacillus cereus with inhibition zones of 13.76 mm and 12.56 mm, respectively. It also had the lowest minimum bactericidal concentration (MBC: 0.78 mg/mL) and minimum inhibitory concentration (MIC: 0.52 mg/mL) against S. aureus. In conclusion, the C. axillaris fruit extracts showed potent antioxidant, xanthine oxidase inhibitory, and antibacterial activities, suggesting their potential for pharmaceutical and nutraceutical applications. Further research should focus on the identification of active compounds and in vivo analysis of pharmacological activities.
1. Introduction
Medicinal compounds derived from plants are vital for human health due to their pharmacological effects [1]. Primary metabolites, such as amino acids, carbohydrates, and fats, play critical roles in various life processes. Secondary metabolites, including saponins, polyphenols, flavonoids, alkaloids, steroids, and terpenoids, possess various pharmacological activities [2,3,4]. Bioassay-guided screening of medicinal plants has led to the discovery of valuable drug molecules that effectively combat life-threatening human diseases [1,5,6,7]. Traditional medicines utilize medicinal plants as crude drugs in various formulations and the compounds isolated from these plants play an important role in the discovery and development of modern drugs, nutraceuticals, functional foods, and cosmetics [8,9]. The increasing resistance of bacterial strains to antibiotics has caused a rise in infectious diseases and the emergence of multi-resistant pathogens [9]. This situation results in higher incidence and death rates due to the lack of accessible and effective medications, coupled with expensive new-generation antibiotics [10]. To address this challenge, exploring the potential of plant materials is crucial. Herbal resources serve as significant reservoirs of active therapeutic compounds and offer promising lead molecules for the development of optimized new drugs. Harnessing these resources can provide more potent antimicrobial drugs, considering the escalating microbial resistance [11].
Xanthine oxidase (XO) is a versatile enzyme found in mammalian tissues and various organisms [12], involved in the metabolic conversion of purine bases into uric acid [13,14]. Excessive XO activity is associated with gout development [15]. Treating gout involves enhancing uric acid excretion or inhibiting its production. Medications like probenecid and allopurinol are used to achieve these goals [13,16]. For acute gout attacks, colchicine, corticosteroids, and NSAIDs are commonly prescribed [17]. Uricase enzymes have potential benefits but are susceptible to destruction by antibodies [18]. XO inhibitors are gaining interest due to their fewer side effects compared to other agents [19]. Allopurinol is the only clinically utilized XO inhibitor, but it has associated side effects. Exploring alternative antigout agents without unwanted side effects is crucial. Traditional use of plants in gout and arthritis treatment has inspired studies on various plant species with anti-gout properties [20,21].
Choerospondias axillaris Roxb. is a small deciduous tree that can reach a maximum height of 20 m (Figure 1A) [22]. It belongs to the Anacardiaceae family and is naturally found in Nepal and the Himalayan region in other countries, specifically in areas ranging from 900 to 2000 m in altitude. This plant commonly thrives in the wild across diverse habitats, including terai, hilly, and mountain forests in countries such as Nepal, India, China, Japan, Thailand, Hong Kong, and Vietnam [23]. C. axillaris is widely distributed in 29 hilly districts of Nepal, with high prevalence in several districts including Bhojpur, Kavre, Lalitpur, Bhaktapur, Kathmandu, Sindhupalchok, Kaski, and Parbat [24]. The fruit of C. axillaris is highly prized for its tangy flavor and is consumed fresh or pickled. It is used as a key ingredient in various food items like fruit tarts and candies [25]. The fruit (3 cm in length) has a whitish fleshy pulp surrounded by a green-yellow leathery outer skin [24]. Dried fruits of C. axillaris are of ethnomedicinal importance and are used in polyherbal formulations in traditional Chinese and Tibetan medicine. These formulations address conditions such as tongue infections, chest pain, fevers, loss of appetite, and also serve as a cardiac tonic [26,27]. In Mongolia, dried fruits are used as a sedative and cardio-tonic agent [28,29]. In Vietnam, the bark is processed into an aqueous extract for topical application in treating burns and wounds [30]. In Laos and Vietnam, the fruit is used to enhance blood circulation and for wine production [31]. Scientific investigations have highlighted the pharmacological effects of C. axillaris fruit, including antioxidant [32] and anti-inflammatory properties [33], potential anti-tumor effects [34], cardioprotective activity [35,36], and anti-angiogenic properties [37]. Various bioactive compounds such as ellagic acid, catechin, ascorbic acid, beta-sitosterol, chrysin, gallic acid, quercetin, epicatechin gallate, protocatechuic acid, and others have been isolated from the fruit, supporting its diverse biological activities [25].

Figure 1.
Photographs of Choerospondias axillaris. (A) Fresh and ripened fruits;(B)dried peel and pulp.
Limited comprehensive studies have explored the antibacterial and xanthine oxidase inhibitory properties of C. axillaris fruit extract, despite claims of its antimicrobial and anti-inflammatory effects [31,37,38,39]. This study aimed at the quantitative estimation of phytochemical contents and preliminary evaluation of the antioxidant, xanthine oxidase inhibitory, and antibacterial activities.
2. Materials and Methods
2.1. Chemical Reagents, Solvents, and Standard Drugs
The following chemicals were used during experiments: DPPH (Thermo Fisher Scientific, India Pvt. Ltd., Mumbai, India), nutrient broth (HiMedia Laboratories Pvt. Ltd., Mumbai, India), Mueller Hinton agar (MHA) (HiMedia Laboratories Pvt. Ltd., Mumbai, India), 3(4,5-dimethylthiazol-2-yl)-2-5-diphenyl tetrazolium bromide (MTT) (Beyotime Biotechnology, Haimen, China), allopurinol (Himedia Laboratories Pvt. Ltd., Mumbai, India), quercetin, dimethyl sulfoxide, ascorbic acid, and Folin–Ciocalteu reagent (Thermo Fisher Scientific, India Pvt. Ltd., Mumbai, India), xanthine oxidase of bovine milk origin, barium chloride (HiMedia Laboratories Pvt. Ltd., Mumbai, India), and xanthine (Sigma Aldrich, Saint Louis, MO, USA). Commercially available antibiotic discs of gentamicin and ciprofloxacin (Microxpress, a division of Tulip Diagnostics Pvt. Ltd., Goa, India) were used as positive controls for antibacterial activities.
2.2. Bacterial Strains
To evaluate the efficacy of ethyl acetate, acetone, methanol, and aqueous extracts derived from the C. axillaris dried fruit against different bacterial strains, a laboratory study utilized a total of eight bacterial species. These included four Gram-positive bacteria; Streptococcus pneumonia (ATCC 49619), Bacilus cereus (ATCC154872), Staphylococcus epidermidis (ATCC 12228), and Staphylococcus aureus (ATCC 25923), and four Gram-negative bacteria; Pseudomonas aeruginosa (ATCC 15442), Salmonella enteritidis (ATCC 155350), Klebsiella pneumonia (ATCC 4352),and Escherichia coli (ATCC 14948). The bacterial strains were sourced from Medicross Laboratory in Butwal, Nepal.
2.3. Collection and Identification of Plant Material
In October 2022, fresh and healthy ripened fruits (Figure 1B) of Choerospondias axillaris Roxb. were purchased from Kalimati market, located in the Kathmandu district of Nepal. Following authentication, a voucher specimen of C. axillaris was preserved at the pharmacognosy laboratory of Crimson College of Technology, Nepal, under the voucher number CCT/HRB/2022-11.
2.4. Extraction of C. axillaris Fruits
Firstly, only the fresh and healthy ripened fruits were washed with water and then placed on a clean cotton cloth in a well-ventilated pharmacognosy laboratory for a period of 14 days to undergo shade drying. During this process, the fruits were left to dry naturally. Once fully dried, the hard seeds were manually removed from each fruit and finely ground using a grinder machine. Next, the finely ground powder of C. axillaris dried fruit was carefully sifted through a 40-mesh size sieve by hand. To extract the bioactive compounds, the powder sample was subjected to a separate extraction process using four different solvents: ethyl acetate, acetone, methanol, and water. To carry out the extraction, a simple and efficient triple cold maceration method was chosen, ensuring an effective extraction of the desired compounds. To be more precise, 50 g of C. axillaris fruit powder were individually placed in separate conical flasks. Each flask contained 500 mL of ethyl acetate, acetone, methanol, and water. The flasks were then subjected to regular shaking every hour for a duration of three days. This ensured thorough mixing and extraction of the desired compounds from the plant material. Following the three-day period, the samples underwent filtration to separate the liquid component (menstruum) from the solid residue (marcs). The marcs were subsequently subjected to additional rounds of soaking, utilizing the same volume of fresh solvent specific to each sample. This iterative process was repeated until three separate collections of extracts were obtained, ensuring a thorough extraction of the desired compounds from the marcs. The collected menstruum samples were mixed well and underwent solvent evaporation using a Rota evaporator (R-210/215, Buchi Labortechnik AG, Flawil, Switzerland) at a controlled temperature of 40 °C and then using vacuum desiccator. Finally, all four different extracts were stored in a refrigerator at a temperature of 4 ± 1 °C until they were ready to be utilized.
2.5. Determination of C. axillaris Dried Fruit Extract Yield
The extract yield of dried fruit from C. axillaris in ethyl acetate, acetone, methanol, and water was determined using the following formula:
2.6. Phytochemical Screening
The extracts were subjected to phytochemical screening in order to determine the presence of various bioactive secondary metabolites, including flavonoids, alkaloids, terpenoids, polyphenols, saponins, tannins, phytosterols, cardiac glycosides, resins, and anthraquinones. The screening was conducted using established methods described in previous studies [40,41,42]. The presence of these metabolites was indicated by a plus (+) sign, while their absence was indicated by a minus (−) sign.
2.7. Quantitative Analysis of Total Flavonoid Content
In order to determine the total flavonoid content in the ethyl acetate, acetone, methanolic, and aqueous extracts of C. axillaris fruits, a well-established method involving aluminum chloride (AlCl3) was employed. The quantification protocol used was adapted from a previous research article [43], with necessary modifications made. To create a standard calibration curve, a sequential serial dilution technique was used to prepare six different concentrations of quercetin dissolved in ethanol. The concentrations ranged from 800 µg/mL to 25 µg/mL in a decreasing order of concentration. Four different plant extract solutions with a concentration of 1 mg/mL were prepared using ethanol as a diluent. The preparation involved mixing 2 mL of the plant extract solution with 8 mL of distilled water in a glass test tube. Next, 0.6 mL of a 5% NaNO2solution was added to the mixture, which was continuously agitated for 5 min. After that, 0.6 mL of 10% AlCl3 solution was added, and the resulting mixture was incubated for 5 min. To this, 4 mL of a 1 M NaOH solution was added, and the final mixture was incubated for approximately 30 min at room temperature. An analogous process was conducted to prepare a blank sample, except that 2 mL of ethanol (the diluent) was used instead of the plant sample solution. Subsequently, all the standard, plant sample, and blank solutions were subjected to analysis using a UV spectrophotometer (1900i double-beam spectrophotometer, Tokyo, Japan), specifically at a wavelength of 415 nm. To ensure precise and dependable measurements, this analysis was carried out in triplicate for each solution [43].
2.8. Quantitative Analysis of Total Phenolic Content
The Folin–Ciocalteu (FC) method, a widely accepted approach, was employed to measure the overall phenolic content in the extracts of C. axillaris fruits, using ethyl acetate, acetone, methanolic, and aqueous extracts. To create a standard calibration curve, a sequential serial dilution technique was used to prepare six different concentrations of gallic acid dissolved in ethanol. The concentrations ranged from 800 µg/mL to 25 µg/mL in a decreasing order of concentration. To create the ethyl acetate, acetone, methanolic, and aqueous extract solutions of the plant, we achieved a concentration of 1 mg/mL using ethanol as the diluent. Next, we thoroughly mixed 2 mL of the plant extract solution with 2 mL of the FC reagent in a glass test tube. Afterward, we added 10 mL of water to the mixture. The mixture solution underwent continuous agitation for 5 min. Following that, we added 2 mL of a 10% Na2CO3 solution to the test tube, and the resulting mixture was then incubated at room temperature for approximately 1 h [44].
2.9. Measurement of Total Carbohydrate Content
To quantify the total carbohydrate content in the C. axillaris ethyl acetate, acetone, methanolic, and aqueous extracts, we utilized a well-established phenol sulfuric acid method. The protocols from a previous research article [45] were followed with minor adjustments. To create a standard calibration curve, a sequential serial dilution technique was used to prepare six different concentrations of glucose dissolved in water. The concentrations ranged from 800 µg/mL to 25 µg/mL in a decreasing order of concentration. For all four different extracts of the plant, a sample solution with a concentration of 1 mg/mL was prepared using water as the diluent. Subsequently, 2 mL of the plant extract solution was thoroughly mixed with 1 mL of a 5% (v/v) phenol solution in a glass test tube. Gradually, 5 mL of 10% H2SO4 was added to the test tube. The mixture solution was subjected to continuous agitation for a duration of 10 min. Following that, the final mixture was incubated in a water bath at 30 °C for 20 min. The same process was repeated to prepare a blank sample, where 2 mL of water was used instead of the plant sample solution. Finally, all the standard plant samples and blank solutions were analyzed in a UV-spectrophotometer at a wavelength of 490 nm, with triplicate measurements [45].
2.10. Evaluation of Antioxidant Activity
To determine the antioxidant potency of C. axillaris ethyl acetate, acetone, methanolic, and aqueous extracts, a widely accepted and simple 1,1-diphenyl-2-picrylhydrazyl (DPPH) free radical scavenging technique was selected. The experimental procedure for this study was adopted from a previously published research article [46] with slight modifications. A DPPH solution with a concentration of 0.1 mM was prepared using ethanol as the diluent. Similarly, stock solutions of standard ascorbic acid (100 µg/mL) and plant extract (1 mg/mL) were prepared using the same diluent. Subsequently, four different concentrations of diluted ascorbic acid solutions (10 µg/mL, 5 µg/mL, 2.5 µg/mL, and 1 µg/mL) and six different concentrations of plant extract solutions (250 μg/mL, 125 μg/mL, 62.50 μg/mL, 31.25 μg/mL, 15.625 μg/mL, and 7.812 μg/mL) were prepared using a serial dilution technique. For the free radical scavenging reaction, 5 mL of DPPH solution was transferred into a glass test tube, followed by the addition of 5 mL of the plant extract solution into the same tube. This reaction was performed separately for each diluted plant extract and standard sample in individual tubes. After thorough mixing, the resulting mixture solutions were incubated for approximately 30 min, ensuring protection from light. The degree of DPPH free radical scavenging by various concentrations of plant extract samples was assessed by measuring the absorbance of plant extract-DPPH solutions using a UV spectrophotometer at 517 nm. Ethanol served as the blank control, while the ascorbic acid solution acted as the positive control. Each measurement was conducted three times. The percentage of free radicals inhibited by each plant extract sample was calculated using the following equation:
Percentage radical scavenged = [(A0 − AS)/A0] × 100%
The equation used for calculating the percentage of free radicals inhibited is based on the absorbance values, where A0 represents the absorbance of the blank control and AS represents the absorbance exhibited by the DPPH-plant mixture. Additionally, the IC50 value, which represents the concentration of the sample in μg/mL required to inhibit 50% of DPPH free radicals, was determined through logarithmic regression analysis by interpolating the data obtained for different concentrations of the plant extract [46].
2.11. Xanthine Oxidase Inhibitory Activity
To explore the potential anti-gout activity of C. axillaris dried fruit extract, a xanthine oxidase inhibitory assay was conducted using a spectrophotometer method [47,48,49].
2.11.1. Preparation of Xanthine, Xanthine Oxidase (XO), and Sample Solution
Initially, a xanthine solution with a concentration of 0.15 mM was prepared by dissolving it in a small amount of NaOH and maintaining a pH of 7.5. The xanthine oxidase solution, with a concentration of 0.2 unit/mL, was adjusted to pH 7.5 using 50 mM potassium phosphate buffer. Similarly, four distinct concentrations of the test and standard samples (400, 200, 100, and 40 µg/mL) were prepared in 50 mM potassium phosphate buffer at pH 7.5 through serial dilution [47,48].
2.11.2. Measurement of Xanthine Oxidase Inhibition
To obtain final concentrations of 100, 50, 25, and 10 µg/mL, 0.25 mL of standard and test solutions at four different concentrations (400, 200, 100, and 40 µg/mL) were individually mixed with 0.375 mL of xanthine solution and an equal volume of 50 mM phosphate buffer (pH 7.5). To start the reaction, a volume of 0.035 mL of XO solution was introduced and allowed to incubate at a temperature of 25 °C for a duration of 10 min. The reaction was halted by adding 0.1 mL of a 1 M HCl. Subsequently, the alteration in absorbance was measured at a wavelength of 295 nm using a UV-visible spectrometer. In order to establish the baseline and control, allopurinol and phosphate buffer were utilized as standard and blank samples, respectively. The entire experiment was conducted in triplicate. The percentage of inhibition of xanthine oxidase was determined using the subsequent formula:
In the formula provided, A0 represents the initial absorbance of the enzyme solution in the absence of any test material, while A1 corresponds to the absorbance of the enzyme solution in the presence of the test material [48,49].
2.12. Antibacterial Activity Screening of C. axillaris Dried Fruit Extracts
2.12.1. Preparation of Plant Extracts and Filter Paper Discs
To create four distinct extract solutions of C. axillaris extract for antimicrobial analysis, 100 mg of each extract was placed into a small vial and mixed thoroughly with 1 mL of DMSO to ensure uniform dissolution. As a result, each 10 µL of the prepared plant-extract solution contained 1 mg of dry extract. Filter paper discs with a diameter of 5 mm were then punched out from Whatman’s No. 1 filter paper using a punching machine. These discs were subsequently sterilized in an autoclave at a temperature of 115 °C for a duration of up to 15 min [6,50].
2.12.2. Development of Muller Hinton Agar (MHA) and Bacterial Strains Sub-Culturing
The widely accepted disc diffusion technique was employed for assessing the antimicrobial properties of C. axillaris fruit ethyl acetate, acetone, methanol, and aqueous extracts. To prepare the growth medium, 19 g of MHA (MuellerHinton agar) powder was dissolved in 500 mL of distilled water. The resulting solution was thoroughly mixed in a conical flask and securely sealed with a clean cotton plug. To ensure proper containment, aluminum foil was wrapped around the flask. For sterilizing the media solution, the prepared conical flask was placed inside an autoclave (S.M. Scientific Instrument Pvt. Ltd., Delhi, India) for a duration of 15 min, adhering to the standard conditions of temperature (121 °C) and pressure (15 lbs). Using a sterile laminar airflow (Indo Sati Scientific Lab Equipments, Haryana, India) environment, the sterilized media was then cooled down to a temperature ranging between 40–50 °C. Following this, the aseptic transfer of the media was carried out into multiple sterile Petri dishes, allowing it to settle. From these Petri dishes, two were selected at random for potential examination of microbial contamination. These selected dishes were incubated for a period of 24 h at a constant temperature of 37 °C. The remaining Petri dishes were preserved by storing them in a refrigerator set at a temperature of 5 °C. To perform sub-culturing of the ATCC strains of bacteria, a sterile inoculating loop was heated using a Bunsen burner and then allowed to cool. Subsequently, the cooled loop was dipped into separate tubes containing bacterial suspensions. Each inoculating loop, carrying a specific bacterial strain, was evenly streaked in a zigzag pattern across the surface of a sterile Petri dish containing MHA (MuellerHinton agar) media. A total of eight distinct bacterial strains were sub-cultured onto separate and appropriately labeled Petri dishes. These Petri dishes were then incubated at a temperature of 37 °C for a duration of one day, to facilitate bacterial growth. Throughout the entire experiment, a sterile and aseptic environment was diligently maintained using laminar airflow to ensure optimal conditions [6,50].
2.12.3. Preparation of Bacterial Suspension/Inoculums
To begin, nutrient broth media was prepared and sterilized. Then, 5 mL of the sterile broth media was aseptically transferred into six separate test tubes, each labeled with the specific bacterial strain being investigated. Subsequently, using a sterile inoculating loop, the corresponding bacterial strains from the sub-cultured Petri dishes were inoculated into their respective test tubes containing the broth media. Finally, the sterile test tubes containing the bacterial strains of B. cereus, S. aureus, S. epidermidis, S. pneumoniae, S. enteritidis, K. pneumonia, P. aeruginosa, and E. coli were transferred to an incubator, set at a constant temperature of 37 °C. They were left to incubate for a period of one day, allowing the bacterial colonies to grow. The turbidity of each bacterial suspension was then compared to a 0.5 McFarland standard solution and adjusted accordingly to achieve the desired level [6,50].
2.12.4. Measurement of Zone of Inhibition (ZOI) against Bacterial Strains
To assess the antibacterial effectiveness of C. axillaris fruit ethyl acetate, acetone, methanol, and aqueous extracts against eight pathogenic bacterial strains, the zone of inhibition (ZOI) was determined and measured in millimeters (mm). To perform this analysis, sterile cotton swabs were immersed in separate tubes containing bacterial suspensions. Subsequently, the cotton swabs loaded with bacteria were streaked across the entire surface of individual sterile Petri dishes containing MHA (MuellerHinton agar) media. To conduct the experiment, a sterile cotton swab was immersed into the labeled tubes containing bacterial suspensions. The swab was then gently streaked across the entire surface of a sterile Petri dish that was loaded with MHA (MuellerHinton agar) media. Multiple Petri dishes were prepared for each bacterial strain, depending on the number of samples to be analyzed. Each Petri dish containing the seeded bacteria was clearly labeled with the corresponding bacterium name. The aforementioned procedure was then repeated for the remaining seven different bacterial strains. Once all the bacterial seeding was completed, each Petri dish was divided into four roughly equal regions. In each region, a commercially available gentamicin and ciprofloxacin standard antibiotic discs (Microxpress, a division of Tulip Diagnostics Pvt. Ltd., Goa, India) and self-prepared filter paper disks were placed at an identical distance from each other. The filter paper disks were loaded with 10 µL of plant extract or a blank control. For the blank control, a uniform amount of 10 µL of DMSO was loaded onto the sterile filter disc. All analyses were conducted in triplicate. Subsequently, the Petri dishes containing the samples were incubated in an incubator (S.M. Scientific Instrument Pvt. Ltd., Delhi, India) at a temperature of 37 °C for a period of one day. The following day, the area of bacterial growth that was inhibited by the plant extracts and standard antibiotic discs under investigation was accurately measured using a Vernier caliper (Sangabery Digital Calipers, New York, NY, USA) [6,50].
2.12.5. Calculation of MIC and MBC
To determine the minimum bactericidal concentration (MBC) and minimum inhibitory concentration (MIC) of C. axillaris extracts against the eight pathogenic bacteria, a widely accepted two-fold serial broth microdilution method was selected. For each extract, a total of eleven small-sized test tubes were sterilized and clearly labeled. Out of these, nine tubes were designated for diluted extract solutions, one for the blank control, and one for the negative control. Using a micropipette, 1.5 mL of sterile MHA (Mueller-Hinton Agar) broth media was transferred into each tube. To create nine different diluted concentrations of the extract solution, nine sterile test tubes were appropriately labeled. A stock solution was prepared in the first test tube, consisting of 2 mL of the extract (200 mg extract per mL) mixed with DMSO. Subsequently, serial half dilutions were performed using a diluent composed of an equal ratio mixture of DMSO and water. This process resulted in the generation of nine different dilutions, ranging from 200 mg/mL to 0.78125 mg/mL. Next, 500 µL of the plant extract solution was meticulously added to the respective broth media tubes, resulting in the creation of nine distinct plant extract-broth media solutions with concentrations ranging from 50 mg/mL to 0.1953125 mg/mL (four-fold dilution). Additionally, each vial was inoculated with a bacterial inoculum containing approximately 1 X 105 CFU/mL. Prior to transfer into the test tubes, the turbidity of each bacterial inoculum was adjusted to match the 0.5 McFarland standards. The tenth tube received 500 µL of diluent and served as a blank control to verify the sterility of the media. Likewise, the eleventh tube was solely inoculated with the bacterial inoculum and used as a negative control to ensure the suitability of the broth media for bacterial growth. Subsequently, all the samples were placed in an incubator set at 37 °C for a duration of 24 h. After this incubation period, the minimum inhibitory concentration (MIC) value of both extracts against the eight different bacteria was determined. The MIC was identified as the lowest concentration of the plant extract solution that completely inhibited bacterial growth in the respective test tube. To assess the viability of bacterial cells, 3(4,5 dimethylthiazol-2-yl)-2-5-diphenyl tetrazolium bromide (MTT)was utilized. The samples were incubated for an additional 2 h at 37 °C, allowing the MTT to react with viable cells. Formazan formation, indicating the metabolic activity of the bacteria, was visually examined [50,51].
To determine the minimum bactericidal concentration (MBC), preserved MHA Petri dishes without any bacteria were activated by incubating them for 45 min at a temperature of 37 °C. Subsequently, the activated Petri dishes were transferred to a sterile room equipped with a continuous laminar airflow system. Following that, samples from each diluted test tube, prepared in a similar manner as in the MIC evaluation, were sub-cultured onto the activated MHA plates. These sub-cultured media were then once again transferred to an incubator and kept at a constant temperature of 37 °C for one day. Finally, the MBC was determined as the lowest concentration of the plant extract sample that completely inhibited bacterial growth on the surface of the media [50].
2.13. Statistical Analysis
All measurements were performed in triplicate, and the results were expressed as the mean ± standard deviation (SD). Statistical analysis was conducted using one-way ANOVA followed by Tukey’s test to determine the significance of differences between the groups. GraphPad Prism 8.4.2 software was used and p-value < 0.05 was considered as statistically significant.
3. Results and Discussion
3.1. Measurement of Extractive Yield Value
The values for the amount of extract obtained from dried fruits of C. axillaris using different solvents (ethyl acetate, acetone, methanol, and water) were determined using Equation (1). The findings are presented in Table 1.

Table 1.
Extractive yield values of C. axillaris dried fruit obtained from ethyl acetate, acetone, methanol, and aqueous extracts.
3.2. Phytochemical Screening
Conducting a qualitative analysis of phytochemicals is an essential step in gathering scientific knowledge regarding the presence of pharmacologically important secondary metabolites in plants. This examination reveals valuable information about the plants’ physiological and medicinal properties, including their potential roles in activities such as anticancer, antidiabetic, antiviral, antihypertensive, antioxidant, immune modulation, and antimicrobial effects [52,53].
The phytochemical screening of C. axillaris fruit samples using different solvents (ethyl acetate, acetone, methanol, and water) revealed the presence of various compounds, including carbohydrates, terpenoids, tannins, cardiac glycosides, flavonoids, resins, proteins/amino acids, and steroids. However, in our study, all the extracts were found to be free of alkaloids, phytosterols, and anthraquinones. Additionally, saponins, tannins, and steroids were absent in the aqueous extract. Interestingly, when reviewing an article related to phytochemical screening, we observed similar results in terms of the presence of carbohydrates and phenols, but opposite findings in relation to the presence of alkaloids in the aqueous extract [54]. Furthermore, the article reported the presence of saponins and tannins, while the absence of terpenoids in the aqueous extract, which contradicts our study’s findings. The results for the phytochemical screening are presented on Table 2.

Table 2.
Result for the phytochemical screening of fruit extract of C. axillaris in ethyl acetate, acetone, methanol, and aqueous solvents.
3.3. Quantitative Analysis of Total Phenol Content
Polyphenol compounds are abundantly present constituents in plants. These compounds contain one or more hydroxyl groups, which enable them to effectively neutralize free radicals. Consequently, the total polyphenol content in many plant species is directly associated with their antioxidant capacity. Numerous scientific studies provide evidence that phenolic compounds have a high capacity to donate hydrogen and act as excellent antioxidant molecules [55]. In our study, the total phenolic content was quantitatively assessed using the Folin–Ciocalteu reagent, and the results were expressed as µg gallic acid equivalent (GAE) per milligram of dry extract. Table 3 presents the data regarding the total phenolic content of various C. axillaris extracts, indicated as micrograms of gallic acid equivalent per milligram of dry extract.

Table 3.
Results for the total phenol content, total flavonoid content, and total carbohydrate content of C. axillaris fruit extracted in different solvents.
Significant variations were observed in the total phenolic content among the four different extracts, with values ranging from 68.28 ± 2.49 μg GAE/mg of dry extract weight for the aqueous extract to 154.91 ± 0.16 μg GAE/mg of dry extract weight for the acetone extract. The analysis of the data presented in Table 3 reveals that the choice of solvent for extraction significantly impacts the extraction of phenolic content from dried fruits of C. axillaris. The statistical analysis further confirms a significant difference (p < 0.05) in the total phenolic content among the different solvents used for extraction. The results clearly demonstrate that the acetone extract exhibited the highest total phenolic content, while the aqueous extract displayed the lowest total phenolic content. In previous research, the total phenolic content of ethanolic extracts from the fruit peel and flesh of C. axillaris was determined to be 112.13 and 31.07 mg GAE/g of dried extract, respectively [56]. Additionally, another study reported a total phenolic content of 118 mg GAE per gram of dry extract in a commercially available C. axillaris leather sugar hydroethanolic extract [57].
3.4. Quantitative Analysis Total Flavonoid Content
Flavonoids constitute a diverse and broad category of natural phenolic compounds. These compounds possess various hydroxyl groups, which contribute to their antioxidant activity. The effectiveness of this activity relies on the ability of flavonoids to donate hydrogen or electrons to free radicals [58]. In our study, we conducted a quantitative analysis of four different extracts of C. axillaris to determine the total flavonoid content. This was achieved by precipitating the extract solution with aluminum chloride (AlCl3) in an alkalinized medium. The results were expressed as µg quercetin equivalent (QE) per milligram of dry extract. The results for the total flavonoid content in the various extracts are displayed in Table 3.
Significant variations were observed in the total flavonoid content among the four different extracts, with values ranging from 41.72 ± 2.40μg QE/mg of dry extract weight for the aqueous extract to 283.84 ± 7.73 μg QE/mg of dry extract weight for the acetone extract. The analysis of the data presented in Table 3 reveals that the choice of solvent for extraction significantly impacts the extraction of flavonoid content from dried fruits of C. axillaris. The statistical analysis further confirms a significant difference (p < 0.05) in the total flavonoid content among the different solvents used for extraction. The results clearly demonstrate that the acetone extract exhibited the highest total flavonoid content, while the aqueous extract displayed the lowest total flavonoid content. In previous research, the total flavonoid content of ethanolic extracts from the fruit peel and flesh of C. axillaris was determined to be 62.13 and 14.96 mg QE per g of dried extract, respectively [56]. Additionally, another study reported a total flavonoid content of 63.17 mg QE per gram of dry extract in a commercially available C. axillaris leather sugar hydroethanolic extract [57]. Thus, it can be observed that total flavonoid content reported in our study was comparatively higher than previous findings.
3.5. Quantitative Analysis Total Carbohydrate Content
Carbohydrates, a diverse group of essential molecules, are extensively produced during photosynthesis and play crucial roles as fundamental components within plant cells. They serve as vital sources of energy, governing metabolic reactions, promoting insulin secretion, acting as key elements in neurotransmitters, and regulating serotonin levels in living organisms [59]. During our investigation, we quantitatively analyzed four different extracts of C. axillaris dried fruit to determine their total carbohydrate content using the phenol-sulfuric method. The results, as displayed in Table 3, indicate the carbohydrate content of each extract in micrograms of glucose equivalent per milligram of dry extract weight.
Significant variations were observed in the total carbohydrate content among the four different extracts, with values ranging from 67.26 ± 1.10 μg glucose equivalent (GE)/mg of dry extract weight for the ethyl acetate extract to 269.96 ± 0.96 μg GE/mg of dry extract weight for the acetone extract. The analysis of the data presented in Table 3 reveals that the choice of solvent for extraction significantly impacts the extraction of carbohydrate content from dried fruits of C. axillaris and extent of carbohydrate extraction increase with increasing polarity of extraction solvent. The statistical analysis further confirms a significant difference (p < 0.05) in the total carbohydrate content among the different solvents used for extraction. The results clearly demonstrate that the aqueous extract exhibited the highest total carbohydrate content, while the ethyl acetate extract displayed the lowest total carbohydrate content. For the first time, comprehensive scientific data regarding the quantitative carbohydrate content of dried fruit from C. axillaris has been documented.
3.6. Evaluation of Antioxidant Potency by Scavenging DPPH Free Radicals
The ability of all the plant extracts to donate hydrogen atoms or electrons to the DPPH free radical was evaluated by observing the bleaching effect on an ethanolic solution of DPPH. The DPPH radical is capable of absorbing UV radiation at a wavelength of 517 nm. The radical scavenging capacity of various extracts from C. axillaris was determined by quantitatively measuring the decrease in absorbance. The introduction of a plant extract containing polyphenols and flavonoids leads to the neutralization of free radicals, resulting in a proportional decrease in DPPH absorbance [60]. Therefore, the quantitative measurement of the decrease in absorbance in an ethanolic DPPH solution was performed after the addition of C. axillaris ethyl acetate, acetone, methanol, and aqueous extracts, in seven different concentrations for each extract. According to the data presented in Table 4, the acetone extract demonstrated the most significant inhibition of DPPH free radicals, reaching a remarkable 93.36% at a concentration of 500 µg/mL. On the other hand, the aqueous extract exhibited the lowest level of free radical inhibition, with only 8.09% observed at the concentration of 7.81 µg/mL.

Table 4.
Results for the DPPH free radical scavenging effect of C. axillaris fruit extracted in different solvents (ethyl acetate, acetone, methanol, and water).
Figure 2 illustrates the IC50 values for the different extracts, including ascorbic acid, which serve as a measure of their effectiveness in inhibiting free radicals. Among the four extracts examined, the acetone dried fruit extract exhibited the most favorable IC50 value of 14.13 µg/mL, followed closely by the ethyl acetate dried fruit extract with an IC50 value of 15.72 µg/mL. In comparison, the standard ascorbic acid displayed an IC50 value of 5.35 µg/mL. From this study we can observe that the extract with higher levels of flavonoids and phenolic compounds demonstrated a strong ability to effectively scavenge free radicals. Moreover, Table 5 provides information on the DPPH free radical scavenging effect exhibited by the standard sample, ascorbic acid. In a prior investigation on the assessment of antioxidant activity in C. axillaris, it was documented that the IC50 values for the hydroethanolic peel and pulp extracts were 91.41 µg/mL and 134.13 µg/mL, respectively [56]. However, a separate study conducted in China reported an IC50 value of 532.9 µg/mL for the aqueous extract of C. axillaris fruit [61].

Figure 2.
Bar diagram depicting IC50 values of four different extracts of C. axillaris dried fruit for DPPH free radical inhibition, along with ascorbic acid.

Table 5.
DPPH inhibition percentage shown by standard sample ascorbic acid at different concentrations.
3.7. Measurement of Xanthine Oxidase Inhibitory Effect of C. axillaris Dried Extract
To investigate the potential antigout effect of dried fruit from C. axillaris, an experiment was conducted. In this experiment, ethyl acetate, acetone, methanol, and aqueous extracts of C. axillaris dried fruit were tested to determine their ability to inhibit xanthine oxidase. Four different concentrations were used for each extract. The results obtained from these tests were also compared to the standard drug allopurinol and are presented in Table 6. It was observed that all the analyzed samples demonstrated a dose-dependent inhibitory effect and maximum XO inhibitory effect (82.25%) was shown by its acetone extract, at the concentration of 100 µg/mL. The IC50 value, which represents the concentration of the extract required to achieve 50% inhibition of xanthine oxidase activity, was determined for all the tested samples. As depicted in Figure 3, among the four extracts examined, the acetone dried fruit extract exhibited the most favorable IC50 value of 20.80 µg/mL, followed closely by the methanol dried fruit extract with an IC50 value of 35.31 µg/mL. In comparison, the standard allopurinol displayed an IC50 value of 6.8 µg/mL. The xanthine oxidase inhibitory effect of C. axillaris dried fruit extracts was reported for the first time. Although antigout effects of C. axillaris dried fruit have not been reported yet, major bioactive constituents isolated from the C. axillaris fruit, such as ellagic acid [62,63], gallic acid [63,64], quercetin, dihydroquercetin [65,66,67,68], catechin [65], and ursolic acid [69,70] have demonstrated notable antigout effects in various in vitro, in silico, and in vivo studies. Consequently, it is strongly advised to pursue a bioassay-guided investigation using animal models to further explore the potential antigout properties of C. axillaris.

Table 6.
Xanthine oxidase inhibitory effect of ethyl acetate, acetone, methanol, and aqueous extracts of C. axillaris fruit, at various concentrations, along with standard allopurinol.

Figure 3.
Bar diagram depicting IC50 values of four different extracts C. axillaris dried fruit for xanthine oxidase enzyme inhibition, along with standard drug allopurinol.
3.8. Evaluation of Antibacterial Effect of C. axillaris Dried Extracts
The antibacterial activity of four different extracts, derived from the dried mature fruit of C. axillaris, at the concentration of 1 mg dry extract/disc, was investigated against a range of pathogenic bacteria, including four strains of Gram-positive bacteria and four strains of Gram-negative bacteria. To obtain quantitative data, the area of bacterial growth on Petri discs, inhibited by both plant extracts and standard antibiotic discs was measured using a Vernier caliper. According to the findings presented in Table 7, this study demonstrated that the ethyl acetate, acetone, and methanol extracts exhibited greater efficacy in inhibiting Gram-positive bacteria compared to Gram-negative bacteria. Interestingly, the aqueous extract demonstrated a higher inhibitory effect against Gram-negative bacteria. Typically, plant extracts tend to have a stronger suppressive effect on Gram-positive bacteria compared to Gram-negative strains. This is attributed to the presence of a multi-layered cell wall with drug-impenetrable lipopolysaccharide architecture in Gram-negative bacteria, which is absent in Gram-positive strains. In addition, Gram-positive bacteria possess a peptidoglycan layer that has a mesh-like structure, making them more vulnerable to the penetration of extracts [71,72].

Table 7.
Results depicting the zone of inhibition obtained against eight different pathogenic bacterial strains after interacting with C. axillaris dried fruit ethyl acetate, acetone, methanol, and aqueous extracts.
As shown in Table 7, the acetone extract from dried fruits of C. axillaris showed significant effectiveness against S. aureus (ZOI-13.76 mm) and B. cereus (ZOI-12.56 mm). However, it exhibited sensitivity only against E. coli, among the Gram-negative bacteria (ZOI-7.89 mm). Similarly, the ethyl acetate extract showed the most prominent inhibitory effect on S. epidermidis (ZOI-11.67 mm). For Gram-negative bacteria, the aqueous extract displayed the strongest suppressive effect on K. pneumoniae (ZOI-11.56 mm). Ethyl acetate and acetone extracts were effective against all examined Gram-positive bacteria, while only the aqueous extract was effective against all investigated Gram-negative bacteria. Notably, E. coli showed sensitivity to all four different extracts among the Gram-negative bacteria. Interestingly, our results revealed that the inhibitory effect on Gram-negative bacteria increased with the extracts obtained from solvents of increasing polarity. In a study conducted in China, using the ethanolic extract of C. axillaris fruit, the peel extract showed measurable inhibitory effects against S. aureus (ZOI-21.75 mm) and E. coli (ZOI-15.00 mm). Similarly, the pulp extract exhibited inhibitory effects with ZOI of 15.00 mm and 10.75 mm against S. aureus and E. coli, respectively. Also, both the peel extract (ZOI-17.00 mm) and pulp extract (ZOI-13.75 mm) demonstrated measurable growth inhibition against B. subtilis. The concentration of the extract used in the study was 2 mg per disc [56]. Here, we investigated the antibacterial potency of C. axillaris dried fruit extracts against other six bacteria for the first time. Figure 4 depicts the ZOI shown by different extracts of C. axillaris fruit against different pathogenic bacteria.
Figure 4.
Photographs depicting ZOI produced different extracts of C. axillaris dried fruits against different bacterial strains ((A) ethyl acetate extract against S. epidemidis; (B) acetone extract against S. aureus; (C) acetone extract against S. epidermidis, and (D) aqueous extract against P. aeruginosa).
Out of the 32 samples (four different extracts individually tested against eight different bacterial strains), 23 samples demonstrated observable zones of inhibition (ZOI). These 23 samples were further analyzed to determine their minimum inhibitory concentration (MIC) and minimum bactericidal concentration (MBC) values, which were measured in milligrams per milliliter (mg/mL). As shown in Table 8, the tested extracts showed a range of minimum inhibitory concentration (MIC) values, varying from 0.52 mg/mL to 8.33 mg/mL, as well as minimum bactericidal concentration (MBC) values ranging from 0.78 mg/mL to 16.66 mg/mL. Out of the extracts analyzed, the acetone extract from C. axillaris demonstrated the highest level of effectiveness against S. aureus. It displayed a minimum inhibitory concentration (MIC) of 0.52 mg/mL and a minimum bactericidal concentration (MBC) of 0.78 mg/mL. Besides, ethyl acetate extract also depicted almost similar efficacy against S. epidermis with MIC and MBC value of 0.65 mg/mL and 1.30 mg/mL, respectively. Conversely, the aqueous extract displayed the highest MIC and MBC value of 8.33 mg/mL and 16.66 mg/mL, respectively, against S. aureus. According to the information presented in Table 8, it was observed that towards all four extracts, only the E. coli bacteria exhibited sensitivity to both inhibitory and bactericidal effects, in examined concentration. Furthermore, concerning Gram-negative bacteria, the aqueous extract demonstrated the highest efficacy against K. pneumonia. It displayed a minimum inhibitory concentration (MIC) value of 1.4 mg/mL and a minimum bactericidal concentration (MBC) value of 2.6 mg/mL. In a study conducted in China, using the ethanolic extract of C. axillaris fruit, the peel extract showed MIC values of 0.16 mg/mL and 5.00 mg/mL against S. aureus and E. coli, respectively. Similarly, the MBC values against S. aureus and E. coli were 1.25 mg/mL and 10.00 mg/mL, respectively [56]. Here, we investigated the inhibitory and bactericidal potency of C. axillaris dried fruit extracts against other six bacteria for the first time. Although bioassay guided antibacterial screening of C. axillaris have not been conducted yet, numerous abundantly present bioactive constituents like ellagic acid, catechin, ascorbic acid, beta-sitosterol, chrysin, gallic acid, quercetin, dihydroquercetin, epicatechin gallate, protocatechuic acid, octacosanol, quercetin, pinocembrin, sinapic acid, salicylic acid, triacontanoic acid, and daucosterol [25] might be responsible for observed antibacterial effect.

Table 8.
Results depicting the MIC and MBC values shown by ethyl acetate, acetone, methanol, and water extracts of C. axillaris extract against eight different pathogenic bacteria.
4. Conclusions
Based on our current results, it can be concluded that the ethyl acetate and acetone extracts obtained from dried fruits of C. axillaris exhibited noteworthy antibacterial and antioxidant properties. These extracts also contained a considerable amount of phenolic and flavonoid compounds. Additionally, the aqueous extract was found to have significant carbohydrate content, suggesting its potential as a nutritional source.In vitro study indicated that the acetone and methanol extracts of C. axillaris dried fruit may be effective in reducing uric acid synthesis by inhibiting the xanthine oxidase enzyme, thereby potentially serving as a treatment option for gout. The presence of polyphenols, terpenoids, and flavonoids in the extracts can be attributed to the observed biological activities.
Considering our findings, we propose the utilization of C. axillaris dried fruit extract as a means to inhibit the growth of both Gram-positive and Gram-negative bacteria. The notable antibacterial efficacy against a range of pathogenic bacteria suggests that this extract holds significant potential in combating various severe infections, including endocarditis, urinary tract infections, pneumonia, dental issues, septicemia, dysentery, otitis, diarrhea, meningitis, and others. However, it is crucial to conduct further comprehensive research using animal models and gain a deeper understanding of the antibacterial mechanism of action in order to validate the traditional use of this plant. Such efforts will contribute to the ongoing research endeavors focused on exploring antibacterial medications derived from medicinal plants, with the ultimate goals of promoting health, ensuring human safety, protection, and advancing scientific knowledge in the field. Furthermore, it is highly recommended to conduct thorough investigations on the dried fruits of C. axillaris using animal models and molecular-level studies to examine its pharmacological activities and identification of bioactive compounds.
Author Contributions
Conceptualization, J.P. and H.P.D.; methodology, J.P.; software, J.P.; investigation, S.N., S.B., A.B., S.T., R.B.K., and J.P.; data curation, J.P.; writing—original draft preparation, J.P.; writing—review and editing, J.P. and H.P.D.; supervision, J.P.; project administration, J.P. and H.P.D. All authors have read and agreed to the published version of the manuscript.
Funding
This research received no external funding.
Institutional Review Board Statement
Not applicable.
Informed Consent Statement
Not applicable.
Data Availability Statement
All the data used to support the results of this research are available from Jitendra Pandey upon request.
Acknowledgments
We are very much grateful to Department of Pharmacy, Crimson College of Technology for all the technical support.
Conflicts of Interest
The authors declare no conflict of interest.
References
- Lonkala, S.; Reddy, A.R. Antibacterial activity of Carica papaya leaves and Allium sativum cloves alone and in combination against multiple strains. Pharmacogn. J. 2019, 11, 600–602. [Google Scholar] [CrossRef]
- Naz, S.; Jabeen, S.; Ilyas, S.; Manzoor, F.; Aslam, F.; Ali, A. Antibacterial activity of Curcuma longa varieties against different strains of bacteria. Pak. J. Bot. 2010, 42, 455–462. [Google Scholar]
- Pandey, J.; Bhusal, S.; Nepali, L.; Khatri, M.; Ramdam, R.; Barakoti, H.; Giri, P.M.; Pant, D.; Aryal, P.; Rokaya, R.K.; et al. Anti-inflammatory activity of Artemisia vulgaris leaves, originating from three different altitudes of Nepal. Sci. World. J. 2021, 2021, 6678059. [Google Scholar] [CrossRef] [PubMed]
- Lamichhane, G.; Pandey, J.; Devkota, H.P. Bioactive chemical constituents and pharmacological activities of Ponciri fructus. Molecules 2023, 28, 255. [Google Scholar] [CrossRef] [PubMed]
- Sai, K.; Poudel, P.; Devkota, H.P. Choerospondiasaxillaris (Roxb.) BLBurtt & AWHill. In Himalayan Fruits and Berries; Academic Press: Cambridge, MA, USA, 2023; pp. 61–69. [Google Scholar]
- Chhetry, A.K.; Dhakal, S.; Chaudhary, L.; Karki, K.; Khadka, R.B.; Chaudhary, G.P.; Bastola, T.; Poudel, A.; Aryal, P.; Pandey, J. Study of antibacterial activity of root bark, leaves, and pericarp extracts of Diploknema butyracea and evaluation of prospective antioxidant activity. J. Tropic. Med. 2022, 2022, 6814901. [Google Scholar] [CrossRef]
- Cutignano, A.; Nuzzo, G.; Ianora, A.; Luongo, E.; Romano, G.; Gallo, C.; Sansone, C.; Aprea, S.; Mancini, F.; D’Oro, U.; et al. Development and application of a novel SPE-method for bioassay-guided fractionation of marine extracts. Mar. Drugs 2015, 13, 5736–5749. [Google Scholar] [CrossRef]
- KC, S.K.; Müller, K. Medicinal plants from Nepal; II. Evaluation as inhibitors of lipid peroxidation in biological membranes. J. Ethnopharmacol. 1999, 64, 135–139. [Google Scholar]
- Hemaiswarya, S.; Kruthiventi, A.K.; Doble, M. Synergism between natural products and antibiotics against infectious diseases. Phytomed 2008, 15, 639–652. [Google Scholar] [CrossRef]
- Akinsulire, O.R.; Aibin, I.E.; Adenipekun, T.; Adelowotan, T.; Odugbemi, T. In vitro antimicrobial activity of crude extracts from plants Bryophyllum pinnatum and Kalanchoe crenata. Afr. J. Trad. Complement. Altern. Med. 2007, 4, 338–344. [Google Scholar] [CrossRef]
- Nascimento, G.G.; Locatelli, J.; Freitas, P.C.; Silva, G.L. Antibacterial activity of plant extracts and phytochemicals on antibiotic-resistant bacteria. Braz. J. Microbiol. 2000, 31, 247–256. [Google Scholar] [CrossRef]
- Cicero, A.F.; Fogacci, F.; Cincione, R.I.; Tocci, G.; Borghi, C. Clinical effects of xanthine oxidase inhibitors in hyperuricemic patients. Med. Princ. Pract. 2021, 30, 122–130. [Google Scholar] [CrossRef] [PubMed]
- Tan, A. Novel 1, 2, 3-triazole compounds: Synthesis, In vitro xanthine oxidase inhibitory activity, and molecular docking studies. J. Mol. Struct. 2020, 121, 128060. [Google Scholar] [CrossRef]
- Singh, J.V.; Bedi, P.M.S.; Singh, H.; Sharma, S. Xanthine oxidase inhibitors: Patent landscape and clinical development (2015–2020). Expert. Opin. Therap. Pat. 2020, 30, 769–780. [Google Scholar] [CrossRef] [PubMed]
- Liu, L.; Zhang, L.; Ren, L.; Xie, Y. Advances in structures required of polyphenols for xanthine oxidase inhibition. Food Front. 2020, 1, 152–167. [Google Scholar] [CrossRef]
- Liang, G.; Nie, Y.; Chang, Y.; Zeng, S.; Liang, C.; Zheng, X.; Xiao, D.; Zhan, S.; Zheng, Q. Protective effects of Rhizoma smilacis glabrae extracts on potassium oxonate-and monosodium urate-induced hyperuricemia and gout in mice. Phytomed 2019, 59, 152772. [Google Scholar] [CrossRef]
- Jiang, J.; Gao, K.; Zhou, Y.; Xu, A.; Shi, S.; Liu, G.; Li, Z. Electroacupuncture treatment improves learning-memory ability and brain glucose metabolism in a mouse model of Alzheimer’s disease: Using morris water maze and micro-PET. Evid-Based Complement. Alt. Med. 2015, 2015, 142129. [Google Scholar] [CrossRef]
- Vasudeva, N.; Singla, P.; Das, S.; Sharma, S.K. Antigout and antioxidant activity of stem and root of Origanum majorana Linn. Am. J. Drug. Discov. Dev. 2014, 4, 102–112. [Google Scholar] [CrossRef]
- Umamaheswari, M.; AsokKumar, K.; Somasundaram, A.; Sivashanmugam, T.; Subhadradevi, V.; Ravi, T.K. Xanthine oxidase inhibitory activity of some Indian medical plants. J. Ethnopharmacol. 2007, 109, 547–551. [Google Scholar] [CrossRef]
- Irawan, C.; Utami, A.; Styani, E.; Putri, I.D.; Putri, R.K.; Dewanta, A.; Ramadhanti, A. Potential of ethanolic extract from ripe Musa balbisiana Colla fruit using ultrasound-assisted extraction as an antioxidant and anti-Gout. Pharmacogn. J. 2021, 13, 1332–1340. [Google Scholar] [CrossRef]
- Daoudi, N.E.; Bouhrim, M.; Ouassou, H.; Bnouham, M. Medicinal plants as a drug alternative source for the antigout therapy in Morocco. Scientifica 2020, 2020, 8637583. [Google Scholar] [CrossRef]
- Labh, S.N.; Shakya, S.R. Medicinal importance of Choerospondias axillaris (Roxb.) Burtt& Hill fruits in Nepal. J. Trop. Plant Res. 2016, 3, 463–469. [Google Scholar]
- Labh, S.N.; Shakya, S.R.; Kayasta, B.L. Extract of Medicinal lapsi Choerospondias axillaris (Roxb.) exhibit antioxidant activities during in vitro studies. J. Pharmacogn. Phytochem. 2015, 4, 194–197. [Google Scholar]
- Paudel, K.C.; Pieber, K.; Klumpp, R.; Laimer, M. Evaluation of Lapsi tree (Choerospondias axillaris, Roxb.) for fruit production in Nepal. Die Bodenkultur. 2003, 54, 3–9. [Google Scholar]
- Mann, S.; Chakraborty, D.; Biswas, S. An alternative perspective of an underutilized fruit tree Choerospondias axillaris in health promotion and disease prevention: A review. Food Biosci. 2022, 14, 101609. [Google Scholar] [CrossRef]
- Wangchuk, P.; Yeshi, K.; Jamphel, K. Pharmacological, ethnopharmacological, and botanical evaluation of subtropical medicinal plants of Lower Kheng region in Bhutan. Integr. Med. Res. 2017, 6, 372–387. [Google Scholar] [CrossRef] [PubMed]
- Li, C.W.; Cui, C.B. One new and nine known flavonoids from Choerospondias axillaries and their in vitro antitumor, anti-hypoxia and antibacterial activities. Molecules 2014, 19, 21363–21377. [Google Scholar] [CrossRef] [PubMed]
- Jin, T. The clinical research of Guangzaofufang capsule on coronary disease. Chin. J. Ethnomed. Ethnopharm. 2011, 16, 12–14. [Google Scholar]
- Tang, W.; Eisenbrand, G. Chinese Drugs of Plant Origin: Chemistry, Pharmacology, and Use in Traditional and Modern Medicine; Springer Science & Business Med: Berlin/Heidelberg, Germany, 2013; pp. 307–308. [Google Scholar]
- Van Sam, H.; Nanthavong, K.; Kessler, P.J. Trees of Laos and Vietnam: A field guide to 100 economically or ecologically important species. Blumea 2004, 49, 201–349. [Google Scholar] [CrossRef]
- Doanh, N.D.; Ham, N.N.; Tam, N.T.; Son, P.T.; van Dau, N.; Grabe, M.; Johansson, R.; Lindgren, G.; Stjernström, N.E.; Söderberg, T.A. The Use of a Water Extract from the Bark of Choerospondias axillaris in the Treatment of Second Decree Burns. Scand. J. Plast. Reconstr. Surg. Hand. Surg. 1996, 30, 139–144. [Google Scholar] [CrossRef]
- Dangal, A.; Timsina, P.; Dahal, S. A comprehensive review on study of physical, nutritional, and phytochemical characteristics as well as therapeutic activities of Choerospondias axillaris (lapsi). Food Biosci. 2023, 53, 102713. [Google Scholar] [CrossRef]
- Mann, S.; Sharma, A.; Sarkar, A.; Kharb, R.; Malhotra, R.; Datta, B.; Gupta, R.K.; Biswas, S. Evaluation of anti-inflammatory effects of Choerospondias axillaris fruit’s methanolic extract in synoviocytes and CIA rat model. Curr. Pharm. Biotechnol. 2020, 21, 596–604. [Google Scholar] [CrossRef] [PubMed]
- Kil, Y.S.; Risinger, A.L.; Petersen, C.L.; Liang, H.; Grkovic, T.; O’Keefe, B.R.; Mooberry, S.L.; Cichewicz, R.H. Using the Cancer Dependency Map to Identify the Mechanism of Action of a Cytotoxic Alkenyl Derivative from the Fruit of Choerospondias axillaris. J. Nat. Prod. 2020, 83, 584–592. [Google Scholar] [CrossRef]
- Li, C.; He, J.; Gao, Y.; Xing, Y.; Hou, J.; Tian, J. Preventive effect of total flavones of Choerospondias axillaries on ischemia/reperfusion-induced myocardial infarction-related MAPK signaling pathway. Cardiovasc. Toxicol. 2014, 14, 145–152. [Google Scholar] [CrossRef] [PubMed]
- Sun, B.; Xia, Q.; Gao, Z. Total flavones of Choerospondias axillaris attenuate cardiac dysfunction and myocardial interstitial fibrosis by modulating NF-κB signaling pathway. Cardiovasc. Toxicol. 2015, 15, 283–289. [Google Scholar] [CrossRef]
- Li, Q.; Wang, X.; Chen, J.; Liu, C.; Li, T.; McClements, D.J.; Dai, T.; Liu, J. Antioxidant activity of proanthocyanidins-rich fractions from Choerospondias axillaris peels using a combination of chemical-based methods and cellular-based assay. Food Chem. 2016, 208, 309–317. [Google Scholar] [CrossRef] [PubMed]
- Chhetri, G.; Bhujel, D.; Rai, Y.K. Ethno-medicinally significant edible wild fruits of Sikkim Himalaya. J. Adv. Plant. Sci. 2020, 10, 45–57. [Google Scholar]
- Quang, C.M. Phytochemical and Pharmacological Evaluation of Choerospondias axillaris, a Vietnamese Medicinal Plant Used to TREAT Burns. Licentiate Thesis, Faculty of Pharmacy, Uppsala University, Uppsala, Sweden, 1994. Monograph 17. [Google Scholar]
- Ayoola, G.A.; Coker, H.A.; Adesegun, S.A.; Adepoju-Bello, A.A.; Obaweya, K.; Ezennia, E.C.; Atangbayila, T.O. Phytochemical screening and antioxidant activities of some selected medicinal plants used for malaria therapy in Southwestern Nigeria. Tropic. J. Pharma. Res. 2008, 7, 1019–1024. [Google Scholar]
- Evans, W.C. Trease and Evans’ Pharmacognosy International Edition E-Book; Elsevier Health Sciences: Amsterdam, The Netharlands, 2009. [Google Scholar]
- Gracelin, D.H.; Britto, A.J.; Kumar, B.J. Qualitative and quantitative analysis of phytochemicals in five Pteris species. Int. J. Pharm. Pharm. Sci. 2013, 5, 105–107. [Google Scholar]
- Shraim, A.M.; Ahmed, T.A.; Rahman, M.M.; Hijji, Y.M. Determination of total flavonoid content by aluminum chloride assay: A critical evaluation. LWT 2021, 150, 111932. [Google Scholar] [CrossRef]
- Sharma, K.R.; Giri, G. Quantification of phenolic and flavonoid content, antioxidant activity, and proximate composition of some legume seeds grown in Nepal. Int. J. Food. Sci. 2022, 2022, 4629290. [Google Scholar] [CrossRef]
- Albalasmeh, A.A.; Berhe, A.A.; Ghezzehei, T.A. A new method for rapid determination of carbohydrate and total carbon concentrations using UV spectrophotometry. Carbohydr. Polym. 2013, 97, 253–261. [Google Scholar] [CrossRef] [PubMed]
- Lamichhane, G.; Sharma, G.; Sapkota, B.; Adhikari, M.; Ghimire, S.; Poudel, P.; Jung, H.J. Screening of antioxidant, antibacterial, anti-adipogenic, and anti-inflammatory activities of five selected medicinal plants of Nepal. J. Exp. Pharmacol. 2023, 15, 93–106. [Google Scholar] [CrossRef] [PubMed]
- Umamaheswari, M.; Asokkumar, K.; Sivashanmugam, A.T.; Remyaraju, A.; Subhadradevi, V.; Ravi, T.K. In vitro xanthine oxidase inhibitory activity of the fractions of Erythrina stricta Roxb. J. Ethnopharmacol. 2009, 124, 646–648. [Google Scholar] [CrossRef] [PubMed]
- Palani, T.; Shobha, K.; Thirunavukkarasu, P.; Hari, R. and in silico antigout arthritic activities of ethanolic and aqueous stem extracts of Cissus quadrangularis—A TLR2 and TLR4 receptor approach. J. Appl. Pharm. Sci. 2018, 8, 15–22. [Google Scholar]
- Owen, P.L.; Johns, T. Xanthine oxidase inhibitory activity of northeastern North American plant remedies used for gout. J. Ethnopharmacol. 1999, 64, 149–160. [Google Scholar] [CrossRef]
- Phuyal, N.; Jha, P.K.; Raturi, P.P.; Rajbhandary, S. In vitro antibacterial activities of methanolic extracts of fruits, seeds, and bark of Zanthoxylum armatum DC. J. Tropic. Med. 2020, 2020, 2803063. [Google Scholar] [CrossRef]
- Al Bratty, M.; Makeen, H.A.; Alhazmi, H.A.; Syame, S.M.; Abdalla, A.N.; Homeida, H.E.; Sultana, S.; Ahsan, W.; Khalid, A. Phytochemical, cytotoxic, and antimicrobial evaluation of the fruits of miswak plant, Salvadora persica L. J. Chem. 2020, 2020, 4251951. [Google Scholar] [CrossRef]
- Aziz, M.M.; Raza, M.A.; Saleem, H.; Wajid, M.; Bashir, K.; Ikram, M. Medicinal values of herbs and plants, importance of phytochemical evaluation and ethnopharmacological screening: An illustrated review essay. J. Pharm. Cosmet. Sci. 2014, 2, 6–10. [Google Scholar]
- Shaikh, J.R.; Patil, M. Qualitative tests for preliminary phytochemical screening: An overview. Int. J. Chem. Stud. 2020, 8, 603–608. [Google Scholar] [CrossRef]
- Baral, R.; Subedi, L.; Gurung, M.; Ojha, S.; Shrestha, B.; Chaudhary, D.; Jammarkattel, N. Phytochemical screening, free radical scavenging activity, in-vitro alpha-amylase enzyme and glucose diffusion inhibition activity of ethyl acetate and water extracts of selected medicinal plants of Nepal. Int. J. Herb. Med. 2021, 9, 18–27. [Google Scholar]
- Yen, G.C.; Duh, P.D.; Tsai, C.L. Relationship between antioxidant activity and maturity of peanut hulls. J. Agric. Food Chem. 1993, 41, 67–70. [Google Scholar] [CrossRef]
- Li, Q.; Chen, J.; Li, T.; Liu, C.; Liu, W.; Liu, J. Comparison of bioactivities and phenolic composition of Choerospondias axillaris peels and fleshes. J. Sci. Food Agric. 2016, 96, 2462–2471. [Google Scholar] [CrossRef]
- KC, Y.; Dangal, A.; Thapa, S.; Rayamajhi, S.; Chalise, K.; Shiwakoti, L.D.; Shiwakoti, R.; Katuwal, N. Nutritional, phytochemicals, and sensory analysis of Lapsi (Choerospondias axillaris) fruit leather. Int. J. Food Prop. 2022, 25, 960–975. [Google Scholar] [CrossRef]
- Pandey, Y.; Upadhyay, S.; Bhatt, S.S. Phytochemical constituent of some wild edible fruits of Sikkim Himalaya. J. Pharmacogn. Phytochem. 2018, 7, 1045–1047. [Google Scholar]
- Tharanathan, R.N.; Muralikrishna, G.; Salimath, P.V.; Rao, M.R. Plant carbohydrates-an overview. Plant Sci. 1987, 7, 81–155. [Google Scholar] [CrossRef]
- Canadanovic-Brunet, J.M.; Djilas, S.M.; Cetkovic, G.S.; Tumbas, V.T. Free-radical scavenging activity of wormwood (Artemisia absinthium L) extracts. J. Sci. Food Agric. 2005, 85, 265–272. [Google Scholar] [CrossRef]
- Wang, H.; Gao, X.D.; Zhou, G.C.; Cai, L.; Yao, W.B. In vitro and in vivo antioxidant activity of aqueous extract from Choerospondias axillaris fruit. Food Chem. 2008, 106, 888–895. [Google Scholar] [CrossRef]
- El-Tantawy, W.H. Natural products for the management of hyperuricaemia and gout: A review. Arch. Physiol. Biochem. 2021, 127, 61–72. [Google Scholar] [CrossRef]
- Choudhary, D.K.; Mishra, A. In vitro and in silico interaction of faba bean (Viciafaba L.) seed extract with xanthine oxidase and evaluation of antioxidant activity as a therapeutic potential. Nat. Product. Res. 2019, 33, 2689–2693. [Google Scholar] [CrossRef]
- Kekilli, E.B.; Orhan, I.E.; Deniz, F.S.; Eren, G.; Emerce, E.; Kahraman, A.; Aysal, I.A. Erodium birandianum Ilarslan&Yurdak. shows anti-gout effect through xanthine oxidase inhibition: Combination of in vitro and in silico techniques and profiling of main components by LC-Q-ToF-MS. Phytochem. Lett. 2021, 43, 80–87. [Google Scholar]
- Chen, W.J.; Wu, Y.; Zhao, X.; Liu, S.; Song, F.R.; Liu, Z.Y.; Liu, Z.Q. Screening the anti-gout traditional herbs from TCM using an in vitro method. Chin. Chem. Lett. 2016, 27, 1701–1707. [Google Scholar] [CrossRef]
- Gupta, A.; Birhman, K.; Raheja, I.; Sharma, S.; Kar, H.K. Quercetin: A wonder bioflavonoid with therapeutic potential in disease management. Asian. Pac. J. Trop. Dis. 2016, 6, 248–252. [Google Scholar] [CrossRef]
- Nutmakul, T. A review on benefits of quercetin in hyperuricemia and gouty arthritis. Saudi Pharm. J. 2022, 30, 918–926. [Google Scholar] [CrossRef] [PubMed]
- Ruiz-Miyazawa, K.W.; Staurengo-Ferrari, L.; Mizokami, S.S.; Domiciano, T.P.; Vicentini, F.T.; Camilios-Neto, D.; Pavanelli, W.R.; Pinge-Filho, P.; Amaral, F.A.; Teixeira, M.M.; et al. Quercetin inhibits gout arthritis in mice: Induction of an opioid-dependent regulation of inflammasome. Inflammopharmacology 2017, 25, 555–570. [Google Scholar] [CrossRef] [PubMed]
- Abu-Gharbieh, E.; Shehab, N.G.; Almasri, I.M.; Bustanji, Y. Antihyperuricemic and xanthine oxidase inhibitory activities of Tribulus arabicus and its isolated compound, ursolic acid: In vitro and in vivo investigation and docking simulations. PLoS ONE 2018, 13, e0202572. [Google Scholar] [CrossRef]
- Lou, D.; Zhang, X.; Jiang, C.; Zhang, F.; Xu, C.; Fang, S.; Shang, X.; Zhang, J.; Yin, Z. 3β, 23-Dihydroxy-12-ene-28-ursolic Acid Isolated from Cyclocaryapaliurus Alleviates NLRP3 Inflammasome-mediated gout via PI3K-AKT-mTOR-dependent autophagy. Evid. Based Complement. Alt. Med. 2022, 2022, 5541232. [Google Scholar]
- Essawi, T.; Srour, M. Screening of some Palestinian medicinal plants for antibacterial activity. J. Ethnopharmacol. 2000, 70, 343–349. [Google Scholar] [CrossRef]
- Lin, J.; Opoku, A.R.; Geheeb-Keller, M.; Hutchings, A.D.; Terblanche, S.E.; Jäger, A.K.; Van Staden, J. Preliminary screening of some traditional zulu medicinal plants for anti-inflammatory and anti-microbial activities. J. Ethnopharmacol. 1999, 68, 267–274. [Google Scholar] [CrossRef] [PubMed]
Disclaimer/Publisher’s Note: The statements, opinions and data contained in all publications are solely those of the individual author(s) and contributor(s) and not of MDPI and/or the editor(s). MDPI and/or the editor(s) disclaim responsibility for any injury to people or property resulting from any ideas, methods, instructions or products referred to in the content. |
© 2023 by the authors. Licensee MDPI, Basel, Switzerland. This article is an open access article distributed under the terms and conditions of the Creative Commons Attribution (CC BY) license (https://creativecommons.org/licenses/by/4.0/).